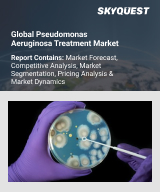

|
시장보고서
상품코드
1879318
감염증 치료제 시장 : 세계 규모, 점유율, 동향 및 기회 = 질환 유형별, 용도별, 지역별 세분화 및 경쟁 구도(2020-2030년)Infectious Disease Therapeutics Market - Global Industry Size, Share, Trends, Opportunity, and Forecast, Segmented By Disease Type, By End Use, By Region, and By Competition, 2020-2030F |
||||||
세계의 감염증 치료제 시장은 2024년에 676억 4,000만 달러로 평가되었고, 2030년까지 연평균 복합 성장률(CAGR) 7.74%로 성장하여 1,058억 달러에 이를 것으로 예측됩니다.
세계 감염병 치료제 시장은 세균, 바이러스, 곰팡이, 기생충 등 병원성 미생물에 의한 질병의 예방, 치료, 관리를 목적으로 하는 의약품 및 의료 개입을 포괄합니다. 시장 확대를 뒷받침하는 주요 요인으로는 전 세계적인 감염병 확산, 항균제 내성의 지속적인 문제, 미충족 의료 수요를 충족시키기 위한 R&D 투자 확대 등을 꼽을 수 있습니다. 또한, 보다 빠르고 정확한 질병을 조기에 발견할 수 있는 진단 기술의 지속적인 발전도 시장 확대의 원동력이 되고 있습니다.
| 시장 개요 | |
|---|---|
| 예측 기간 | 2026-2030년 |
| 시장 규모 : 2024년 | 676억 4,000만 달러 |
| 시장 규모 : 2030년 | 1,058억 달러 |
| CAGR : 2025-2030년 | 7.74% |
| 성장 속도가 가장 빠른 부문 | 병원 |
| 최대 시장 | 북미 |
주요 시장 성장 촉진요인
주요 시장 과제
주요 시장 동향
자주 묻는 질문
목차
제1장 개요
제2장 조사 방법
제3장 주요 요약
제4장 고객의 소리
제5장 세계의 감염증 치료제 시장 전망
- 시장 규모와 예측
- 금액별
- 시장 점유율과 예측
- 질환별(HIV, 간염, 인플루엔자, 결핵, 말라리아, HPV, 기타)
- 용도별(병원, 진료소, 기타)
- 지역별
- 기업별(2024년)
- 시장 맵
제6장 북미의 감염증 치료제 시장 전망
- 시장 규모와 예측
- 시장 점유율과 예측
- 북미 : 국가별 분석
- 미국
- 캐나다
- 멕시코
제7장 유럽의 감염증 치료제 시장 전망
- 시장 규모와 예측
- 시장 점유율과 예측
- 유럽 : 국가별 분석
- 독일
- 프랑스
- 영국
- 이탈리아
- 스페인
제8장 아시아태평양의 감염증 치료제 시장 전망
- 시장 규모와 예측
- 시장 점유율과 예측
- 아시아태평양 : 국가별 분석
- 중국
- 인도
- 일본
- 한국
- 호주
제9장 중동 및 아프리카의 감염증 치료제 시장 전망
- 시장 규모와 예측
- 시장 점유율과 예측
- 중동 및 아프리카 : 국가별 분석
- 사우디아라비아
- 아랍에미리트(UAE)
- 남아프리카공화국
제10장 남미의 감염증 치료제 시장 전망
- 시장 규모와 예측
- 시장 점유율과 예측
- 남미 : 국가별 분석
- 브라질
- 콜롬비아
- 아르헨티나
제11장 시장 역학
- 성장 촉진요인
- 과제
제12장 시장 동향과 발전
- 인수합병(M&A)
- 제품 출시
- 최근 동향
제13장 세계의 감염증 치료제 시장 : SWOT 분석
제14장 Porter의 Five Forces 분석
- 업계내 경쟁
- 신규 참여 가능성
- 공급업체의 힘
- 고객의 힘
- 대체품의 위협
제15장 경쟁 구도
- Novartis AG
- Gilead Sciences Inc
- GSK PLC
- Johnson & Johnson Innovative Medicine
- F Hoffmann-La Roche AG
- BioCryst Pharmaceuticals Inc
- Merck & Co Inc
- Boehringer Ingelheim International GmbH
제16장 전략적 제안
제17장 회사 소개 및 면책조항
LSH 25.12.15The Global Infectious Disease Therapeutics Market, valued at USD 67.64 Billion in 2024, is projected to experience a CAGR of 7.74% to reach USD 105.80 Billion by 2030. The Global Infectious Disease Therapeutics Market encompasses pharmaceutical agents and medical interventions designed for the prevention, treatment, and management of illnesses caused by pathogenic microorganisms, including bacteria, viruses, fungi, and parasites. Key drivers supporting market expansion include the increasing global prevalence of infectious diseases, the persistent challenge of antimicrobial resistance, and growing investments in research and development to address unmet medical needs. Further impetus comes from continuous advancements in diagnostic technologies enabling earlier and more precise disease identification.
| Market Overview | |
|---|---|
| Forecast Period | 2026-2030 |
| Market Size 2024 | USD 67.64 Billion |
| Market Size 2030 | USD 105.80 Billion |
| CAGR 2025-2030 | 7.74% |
| Fastest Growing Segment | Hospitals |
| Largest Market | North America |
Key Market Drivers
The increasing global burden of infectious diseases fundamentally drives market expansion, creating persistent and widespread demand for effective treatments and preventative measures. Diseases like tuberculosis and malaria continue to exact a significant toll on global health, necessitating ongoing research and development into novel pharmacological agents and improved therapeutic strategies. The sheer scale of these challenges ensures a consistent market for diagnostics, drugs, and vaccines, as healthcare systems grapple with endemic infections and outbreaks. According to the World Health Organization, in its Global Tuberculosis Report 2023, an estimated 10.6 million people fell ill with tuberculosis worldwide in 2022, underscoring the critical need for continued therapeutic interventions. This sustained disease pressure compels pharmaceutical companies to invest in developing new therapies to address unmet medical needs.
Key Market Challenges
A significant challenge impeding the growth of the Global Infectious Disease Therapeutics Market is the substantial costs associated with drug discovery and development. Bringing new pharmaceutical agents from initial research to market approval demands extensive financial outlays for preclinical studies, multiple phases of clinical trials, and manufacturing infrastructure. This immense capital requirement significantly raises the barrier to entry for innovators and imposes considerable financial risk on companies, influencing strategic decisions about which therapeutic areas to prioritize.
Key Market Trends
The application of Artificial Intelligence (AI) in drug discovery is significantly reshaping the development landscape for infectious disease therapeutics. AI algorithms are increasingly employed to accelerate the identification of novel drug targets, optimize compound synthesis, and predict drug efficacy and toxicity with greater precision and speed, thereby reducing the time and cost associated with traditional drug development. This technological integration is poised to streamline the discovery of urgently needed treatments for evolving pathogens. According to a survey from Rackspace Technology and Dell/VMware, conducted in October 2023, two out of three pharmaceutical companies (67%) planned to increase their investment in information technology, including artificial intelligence, over the subsequent 12 months. This substantial industry-wide commitment to AI is expected to catalyze innovation across all therapeutic areas, including infectious diseases, by enhancing the efficiency of research and development pipelines.
Key Market Players
- Novartis AG
- Gilead Sciences Inc
- GSK PLC
- Johnson & Johnson Innovative Medicine
- F Hoffmann-La Roche AG
- BioCryst Pharmaceuticals Inc
- Merck & Co Inc
- Boehringer Ingelheim International GmbH
Report Scope:
In this report, the Global Infectious Disease Therapeutics Market has been segmented into the following categories, in addition to the industry trends which have also been detailed below:
Infectious Disease Therapeutics Market, By Disease Type:
- HIV
- Hepatitis
- Influenza
- TB
- Malaria
- HPV
- Others
Infectious Disease Therapeutics Market, By End Use:
- Hospitals
- Clinics
- Others
Infectious Disease Therapeutics Market, By Region:
- North America
- United States
- Canada
- Mexico
- Europe
- France
- United Kingdom
- Italy
- Germany
- Spain
- Asia Pacific
- China
- India
- Japan
- Australia
- South Korea
- South America
- Brazil
- Argentina
- Colombia
- Middle East & Africa
- South Africa
- Saudi Arabia
- UAE
Competitive Landscape
Company Profiles: Detailed analysis of the major companies presents in the Global Infectious Disease Therapeutics Market.
Available Customizations:
Global Infectious Disease Therapeutics Market report with the given market data, TechSci Research offers customizations according to a company's specific needs. The following customization options are available for the report:
Company Information
- Detailed analysis and profiling of additional market players (up to five).
Table of Contents
1. Product Overview
- 1.1. Market Definition
- 1.2. Scope of the Market
- 1.2.1. Markets Covered
- 1.2.2. Years Considered for Study
- 1.2.3. Key Market Segmentations
2. Research Methodology
- 2.1. Objective of the Study
- 2.2. Baseline Methodology
- 2.3. Key Industry Partners
- 2.4. Major Association and Secondary Sources
- 2.5. Forecasting Methodology
- 2.6. Data Triangulation & Validation
- 2.7. Assumptions and Limitations
3. Executive Summary
- 3.1. Overview of the Market
- 3.2. Overview of Key Market Segmentations
- 3.3. Overview of Key Market Players
- 3.4. Overview of Key Regions/Countries
- 3.5. Overview of Market Drivers, Challenges, Trends
4. Voice of Customer
5. Global Infectious Disease Therapeutics Market Outlook
- 5.1. Market Size & Forecast
- 5.1.1. By Value
- 5.2. Market Share & Forecast
- 5.2.1. By Disease Type (HIV, Hepatitis, Influenza, TB, Malaria, HPV, Others)
- 5.2.2. By End Use (Hospitals, Clinics, Others)
- 5.2.3. By Region
- 5.2.4. By Company (2024)
- 5.3. Market Map
6. North America Infectious Disease Therapeutics Market Outlook
- 6.1. Market Size & Forecast
- 6.1.1. By Value
- 6.2. Market Share & Forecast
- 6.2.1. By Disease Type
- 6.2.2. By End Use
- 6.2.3. By Country
- 6.3. North America: Country Analysis
- 6.3.1. United States Infectious Disease Therapeutics Market Outlook
- 6.3.1.1. Market Size & Forecast
- 6.3.1.1.1. By Value
- 6.3.1.2. Market Share & Forecast
- 6.3.1.2.1. By Disease Type
- 6.3.1.2.2. By End Use
- 6.3.1.1. Market Size & Forecast
- 6.3.2. Canada Infectious Disease Therapeutics Market Outlook
- 6.3.2.1. Market Size & Forecast
- 6.3.2.1.1. By Value
- 6.3.2.2. Market Share & Forecast
- 6.3.2.2.1. By Disease Type
- 6.3.2.2.2. By End Use
- 6.3.2.1. Market Size & Forecast
- 6.3.3. Mexico Infectious Disease Therapeutics Market Outlook
- 6.3.3.1. Market Size & Forecast
- 6.3.3.1.1. By Value
- 6.3.3.2. Market Share & Forecast
- 6.3.3.2.1. By Disease Type
- 6.3.3.2.2. By End Use
- 6.3.3.1. Market Size & Forecast
- 6.3.1. United States Infectious Disease Therapeutics Market Outlook
7. Europe Infectious Disease Therapeutics Market Outlook
- 7.1. Market Size & Forecast
- 7.1.1. By Value
- 7.2. Market Share & Forecast
- 7.2.1. By Disease Type
- 7.2.2. By End Use
- 7.2.3. By Country
- 7.3. Europe: Country Analysis
- 7.3.1. Germany Infectious Disease Therapeutics Market Outlook
- 7.3.1.1. Market Size & Forecast
- 7.3.1.1.1. By Value
- 7.3.1.2. Market Share & Forecast
- 7.3.1.2.1. By Disease Type
- 7.3.1.2.2. By End Use
- 7.3.1.1. Market Size & Forecast
- 7.3.2. France Infectious Disease Therapeutics Market Outlook
- 7.3.2.1. Market Size & Forecast
- 7.3.2.1.1. By Value
- 7.3.2.2. Market Share & Forecast
- 7.3.2.2.1. By Disease Type
- 7.3.2.2.2. By End Use
- 7.3.2.1. Market Size & Forecast
- 7.3.3. United Kingdom Infectious Disease Therapeutics Market Outlook
- 7.3.3.1. Market Size & Forecast
- 7.3.3.1.1. By Value
- 7.3.3.2. Market Share & Forecast
- 7.3.3.2.1. By Disease Type
- 7.3.3.2.2. By End Use
- 7.3.3.1. Market Size & Forecast
- 7.3.4. Italy Infectious Disease Therapeutics Market Outlook
- 7.3.4.1. Market Size & Forecast
- 7.3.4.1.1. By Value
- 7.3.4.2. Market Share & Forecast
- 7.3.4.2.1. By Disease Type
- 7.3.4.2.2. By End Use
- 7.3.4.1. Market Size & Forecast
- 7.3.5. Spain Infectious Disease Therapeutics Market Outlook
- 7.3.5.1. Market Size & Forecast
- 7.3.5.1.1. By Value
- 7.3.5.2. Market Share & Forecast
- 7.3.5.2.1. By Disease Type
- 7.3.5.2.2. By End Use
- 7.3.5.1. Market Size & Forecast
- 7.3.1. Germany Infectious Disease Therapeutics Market Outlook
8. Asia Pacific Infectious Disease Therapeutics Market Outlook
- 8.1. Market Size & Forecast
- 8.1.1. By Value
- 8.2. Market Share & Forecast
- 8.2.1. By Disease Type
- 8.2.2. By End Use
- 8.2.3. By Country
- 8.3. Asia Pacific: Country Analysis
- 8.3.1. China Infectious Disease Therapeutics Market Outlook
- 8.3.1.1. Market Size & Forecast
- 8.3.1.1.1. By Value
- 8.3.1.2. Market Share & Forecast
- 8.3.1.2.1. By Disease Type
- 8.3.1.2.2. By End Use
- 8.3.1.1. Market Size & Forecast
- 8.3.2. India Infectious Disease Therapeutics Market Outlook
- 8.3.2.1. Market Size & Forecast
- 8.3.2.1.1. By Value
- 8.3.2.2. Market Share & Forecast
- 8.3.2.2.1. By Disease Type
- 8.3.2.2.2. By End Use
- 8.3.2.1. Market Size & Forecast
- 8.3.3. Japan Infectious Disease Therapeutics Market Outlook
- 8.3.3.1. Market Size & Forecast
- 8.3.3.1.1. By Value
- 8.3.3.2. Market Share & Forecast
- 8.3.3.2.1. By Disease Type
- 8.3.3.2.2. By End Use
- 8.3.3.1. Market Size & Forecast
- 8.3.4. South Korea Infectious Disease Therapeutics Market Outlook
- 8.3.4.1. Market Size & Forecast
- 8.3.4.1.1. By Value
- 8.3.4.2. Market Share & Forecast
- 8.3.4.2.1. By Disease Type
- 8.3.4.2.2. By End Use
- 8.3.4.1. Market Size & Forecast
- 8.3.5. Australia Infectious Disease Therapeutics Market Outlook
- 8.3.5.1. Market Size & Forecast
- 8.3.5.1.1. By Value
- 8.3.5.2. Market Share & Forecast
- 8.3.5.2.1. By Disease Type
- 8.3.5.2.2. By End Use
- 8.3.5.1. Market Size & Forecast
- 8.3.1. China Infectious Disease Therapeutics Market Outlook
9. Middle East & Africa Infectious Disease Therapeutics Market Outlook
- 9.1. Market Size & Forecast
- 9.1.1. By Value
- 9.2. Market Share & Forecast
- 9.2.1. By Disease Type
- 9.2.2. By End Use
- 9.2.3. By Country
- 9.3. Middle East & Africa: Country Analysis
- 9.3.1. Saudi Arabia Infectious Disease Therapeutics Market Outlook
- 9.3.1.1. Market Size & Forecast
- 9.3.1.1.1. By Value
- 9.3.1.2. Market Share & Forecast
- 9.3.1.2.1. By Disease Type
- 9.3.1.2.2. By End Use
- 9.3.1.1. Market Size & Forecast
- 9.3.2. UAE Infectious Disease Therapeutics Market Outlook
- 9.3.2.1. Market Size & Forecast
- 9.3.2.1.1. By Value
- 9.3.2.2. Market Share & Forecast
- 9.3.2.2.1. By Disease Type
- 9.3.2.2.2. By End Use
- 9.3.2.1. Market Size & Forecast
- 9.3.3. South Africa Infectious Disease Therapeutics Market Outlook
- 9.3.3.1. Market Size & Forecast
- 9.3.3.1.1. By Value
- 9.3.3.2. Market Share & Forecast
- 9.3.3.2.1. By Disease Type
- 9.3.3.2.2. By End Use
- 9.3.3.1. Market Size & Forecast
- 9.3.1. Saudi Arabia Infectious Disease Therapeutics Market Outlook
10. South America Infectious Disease Therapeutics Market Outlook
- 10.1. Market Size & Forecast
- 10.1.1. By Value
- 10.2. Market Share & Forecast
- 10.2.1. By Disease Type
- 10.2.2. By End Use
- 10.2.3. By Country
- 10.3. South America: Country Analysis
- 10.3.1. Brazil Infectious Disease Therapeutics Market Outlook
- 10.3.1.1. Market Size & Forecast
- 10.3.1.1.1. By Value
- 10.3.1.2. Market Share & Forecast
- 10.3.1.2.1. By Disease Type
- 10.3.1.2.2. By End Use
- 10.3.1.1. Market Size & Forecast
- 10.3.2. Colombia Infectious Disease Therapeutics Market Outlook
- 10.3.2.1. Market Size & Forecast
- 10.3.2.1.1. By Value
- 10.3.2.2. Market Share & Forecast
- 10.3.2.2.1. By Disease Type
- 10.3.2.2.2. By End Use
- 10.3.2.1. Market Size & Forecast
- 10.3.3. Argentina Infectious Disease Therapeutics Market Outlook
- 10.3.3.1. Market Size & Forecast
- 10.3.3.1.1. By Value
- 10.3.3.2. Market Share & Forecast
- 10.3.3.2.1. By Disease Type
- 10.3.3.2.2. By End Use
- 10.3.3.1. Market Size & Forecast
- 10.3.1. Brazil Infectious Disease Therapeutics Market Outlook
11. Market Dynamics
- 11.1. Drivers
- 11.2. Challenges
12. Market Trends & Developments
- 12.1. Merger & Acquisition (If Any)
- 12.2. Product Launches (If Any)
- 12.3. Recent Developments
13. Global Infectious Disease Therapeutics Market: SWOT Analysis
14. Porter's Five Forces Analysis
- 14.1. Competition in the Industry
- 14.2. Potential of New Entrants
- 14.3. Power of Suppliers
- 14.4. Power of Customers
- 14.5. Threat of Substitute Products
15. Competitive Landscape
- 15.1. Novartis AG
- 15.1.1. Business Overview
- 15.1.2. Products & Services
- 15.1.3. Recent Developments
- 15.1.4. Key Personnel
- 15.1.5. SWOT Analysis
- 15.2. Gilead Sciences Inc
- 15.3. GSK PLC
- 15.4. Johnson & Johnson Innovative Medicine
- 15.5. F Hoffmann-La Roche AG
- 15.6. BioCryst Pharmaceuticals Inc
- 15.7. Merck & Co Inc
- 15.8. Boehringer Ingelheim International GmbH
16. Strategic Recommendations
17. About Us & Disclaimer
(주말 및 공휴일 제외)